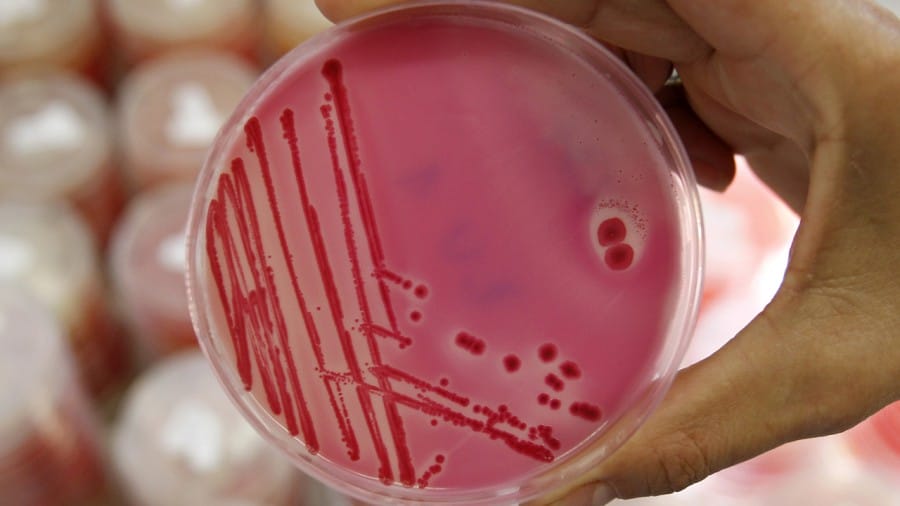

Kalau kamu belum mengetahui apa itu kefir dan beberapa hal umum tentang kefir, kamu bisa membacanya pada artikel sebelumnya. Dalam artikel ini akan dibahas mengenai berbagai bukti bahwa kefir memiliki manfaat yang sangat besar.
Buat kamu yang baru pertama kali akan mencoba kefir murni, siapkan lidah kamu. Rasa asam kefir jauh berlipas – lipat bedanya dari yogurt. Minum sedikit – demi sedikit agar lidah dan indera cium (hidung) kamu dapat beradaptasi hingga terbiasa.
Tentu saja kamu juga bisa mencampurnya dengan berbagai jus buah kesukaan kamu. Misalnya kamu campur dengan jus stroberi, alpukat atau jus lainnya. Cobalah mencampur kefir dengan jus nanas karena dapat ‘menghilangkan’ bau dan rasa ‘aneh’.
Karena citarasa yang menyengat dan tidak lazim ini, kefir memang tidak disukai oleh banyak orang. Penikmat kefir di Indonesia umumnya orang – orang yang memiliki keluhan kesehatan tertentu.
Meskipun begitu, beberapa bukti manfaat kesehatan kefir di bawah ini bisa jadi mengubah persepsi kamu tentang kefir. Jangan ragu untuk menikmati minuman kefir. Karena kefir itu sehat!
Sumber Nutrisi yang Beragam

Dalam sajian minuman susu kefir sebanyak 175 mili liter, terkandung berbagai jenis nutrisi yang baik untuk kesehatan tubuh kamu. Diantaranya adalah protein sebanyak 6 gram dan kalsium sebanyak 20 % dari recommended dietary allowance (RDA).
Selain itu, terdapat juga fosfor sebanyak 20% dari RDA, vitamin B12 sebanyak 14% dari RDA, riboflavin (B2) sebanyak 19% dari RDA, magnesium sebanyak 5% dari RDA dan vitamin D pada jumlah yang cukup.
Nah, yang dimaksud RDA adalah estimasi jumlah nutrisi atau kalori per hari yang diumumkan oleh Food and Nutrition Board of National Research Council atau National Academy of Sciences.
Potensi Kandungan Antibakterial
Beberapa bakteri proiotik pada kefir dipercaya dapat melindungi tubuh dari infeksi. Salah satunya adalah bakteri unik khas kefir yaitu bakteri asam laktat dengan nama Lactobacillus kefiri.
Bakteri probiotik dalam kefir telah diteliti dan hasilnya menunjukkan kemampuan penghambatan pada bakteri berbahaya seperti Salmonella, Escherichia coli dan Helicobacter Pylori. Kefiran (karbohidrat dalam kefir) juga merupakan antibakterial.
Mengurangi Resiko Osteoporosis

Bukti fantastis lainnya adalah bahwa kefir dapat meningkatkan kesehatan tulang. Meinuman kefir yang terbuat dari susu tinggi lemak bukan hanya merupakan sumber kalsium, namun juga sumber vitamin K2.
Apa itu vitamin K2? Pada German Scientific Journal, senyawa ini disebut Koagulations vitamin. Nutrisi yang satu ini berperan penting dalam metabolisme kalsium dan mengurangi resiko patah (fracture) tulang hingga 81%.
Potensi Proteksi Kanker

Penelitian yang diterbitkan lewat British Food Journal menyebutkan bahwa probiotik dalam produk susu dapat menghambat pertumbuhan tumor dengan cara mengurangi pembentukan senyawa karsinogen dan memperkuat sistem imun.
Sementara itu, penelitian lain yang dirilis oleh Journal of Medicinal Food menyebutkan bahwa ekstrak kefir dapat mengurangi jumlah sel kanker payudara pada manusia hingga level 56%.
Sedangkan pada penelitian yang sama, pembandingnya yogurt hanya dapat mengurangi jumlah sel kanker payudara sebanyak 14%.
Cocok Untuk Lactose Intolerant

Banyak orang yang mengalami lactose intolerant, kodisi ini adalah ketika gula laktosa tidak dapat dicerna dengan baik. Akibatnya orang yang mengalami lactose intolerant menjadi alergi dan kadang muntah saat meminum susu.
Padahal dalam susu terdapat banyak nutrisi yang baik untuk tubuh. Nah, dengan produk fermentasi seperti kefir, orang yang mengalami lactose intolerant tetap dapat meminum produk olahan susu berupa minuman kefir.